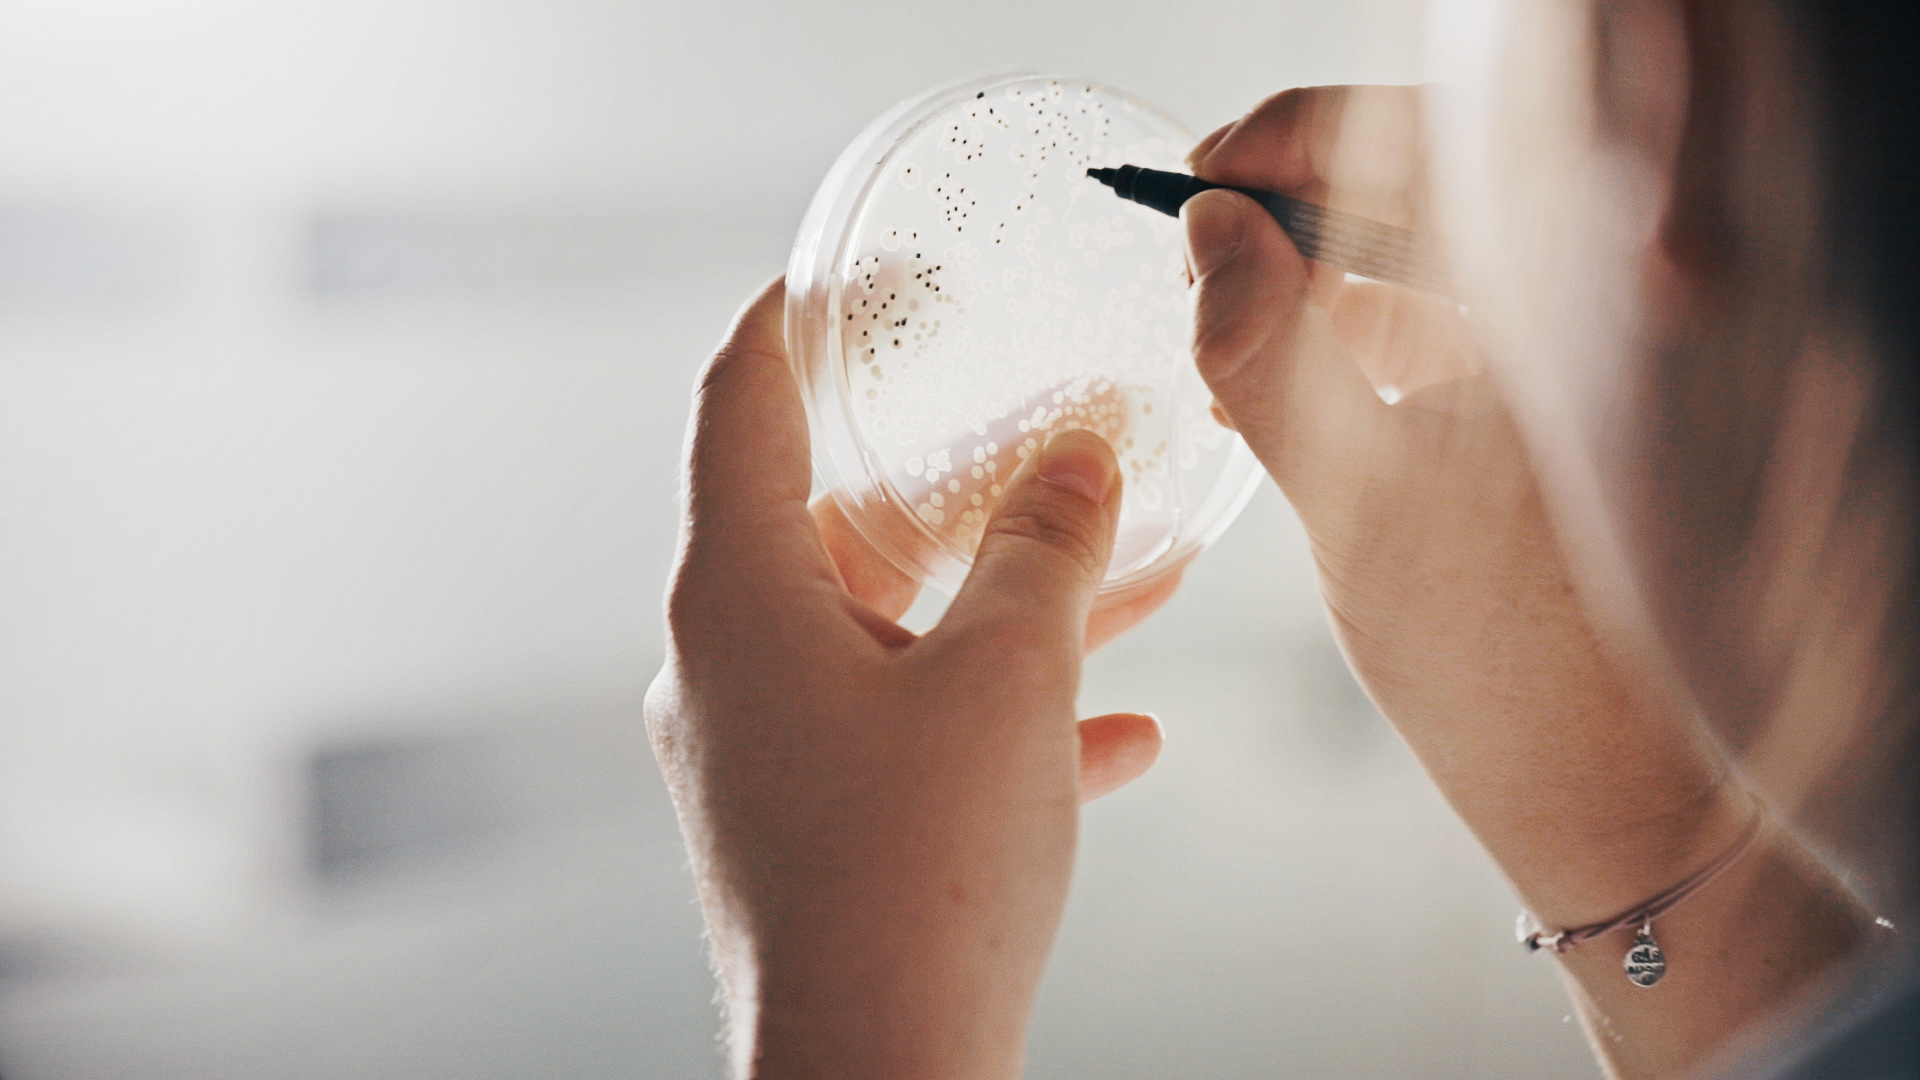

Elephant Vert was born from the conviction of its founder of the urgency to deploy a new agricultural model: good for men, good for the soil and good for the planet. With strong roots in Africa and Europe, and a multicultural approach focused on the human, Elephant Vert has been built on an ethical and responsible commitment to provide agricultural producers with solutions that meet their needs.
Director: Günther Gheeraert
Assistant: Gary Queruel
Production: blacknegative
Client: Elephant Vert
Assistant: Gary Queruel
Production: blacknegative
Client: Elephant Vert
Camera: Canon 5D MkIV
Lenses: Canon 24mm 2.8, 100mm 2.8, 70-300mm Sigma Art 50mm 1.4
Lenses: Canon 24mm 2.8, 100mm 2.8, 70-300mm Sigma Art 50mm 1.4
Shot in Senegal, Morocco and France.